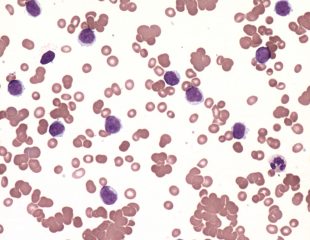

آنتی بادی
تست آگلوتینین سرد
برای بررسی وضعیت هایی که در بدن انواع خاصی آنتی بادی تولید می شود، کاربرد دارد
نسخه

تست های آنتی بادی ( تست کومبس )
تست های آنتی بادی ( تست کومبس ) برای یافتن آنتی بادی هایی که به گلبول های قرمز خون حمله ...
نسخه
مطالب ویژه نسخه

مصرف بیش از حد این 8 ماده غذایی بینهایت خطرناک است

شیرین کننده مصنوعی چیست، فواید و مضرات آن کدام است؟

14 دلیلی که نشان میدهد چرا شما همیشه گرسنه هستید

قبل از اهدای خون چه چیزی بخوریم و چه چیزی نخوریم

چند نکته مهم در تعیین اهداف و رشد شخصی (بخش اول)
آخرین مطالب


لیست بهترین متخصص ارتودنسی در چیذر و نواحی اطراف آن


لیست متخصص ارتودنسی در دروس و اطراف آن

کلیه حقوق این وب سایت متعلق به وب سایت نسخه می باشد. طراحی وب سایت و سئو توسط استدیو نت ابزار



